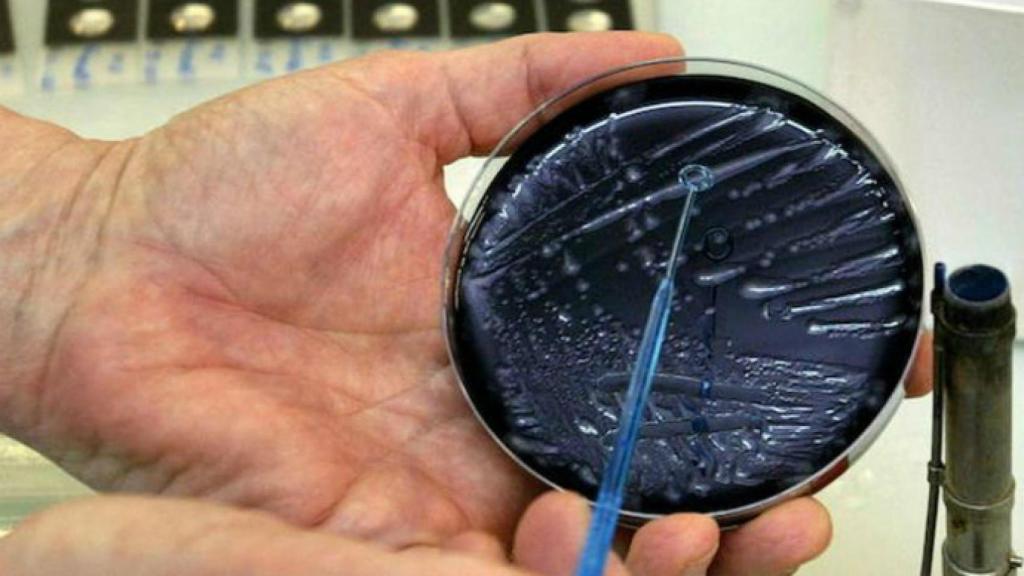
Digital Castilla

Digital Castilla
Mueren dos personas afectadas por un brote de legionella
Dos personas de edad avanzada y con una patología grave previa han muerto en Llinars del Vallès (Barcelona) en los últimos días por un brote de legionella que ha afectado a otros tres ancianos, actualmente ingresados, según ha informado la Conselleria de Salud de la Generalitat de Cataluña.
Los afectados, tres hombres y dos mujeres, iniciaron los síntomas entre el 15 y el 28 de octubre, y la Agencia de Salud Pública de Cataluña (Aspcat) investiga el brote junto al Ayuntamiento de Llinars del Vallès.
Las investigaciones ambiental y epidemiológica se iniciaron el mismo día de la notificación de los enfermos, y se recogió información clínica y epidemiológica necesaria para delimitar dónde se contagiaron e inspeccionaron las instalaciones de riesgo, como torres industriales de refrigeración de agua, y se recogieron muestras de estas instalaciones para analizar.
También se ha ordenado limpiar y desinfectar los circuitos implicados en la investigación, de los que también se han recogido muestras, a la espera de los resultados analíticos que orienten sobre el origen.
El ayuntamiento de la localidad ha dejado sin actividad elementos que facilitan la aspersión importante de agua, como fuentes ornamentales, riegos y vehículos de limpieza viaria.
14 días de incubación
La Conselleria no descarta que pueda aumentar el número de afectados en los próximos días porque el periodo de incubación de la enfermedad puede ser de hasta 14 días.
La Aspcat ha reforzado las actividades de vigilancia epidemiológica y las de investigación ambiental, además de informar a los centros sanitarios de la zona.



